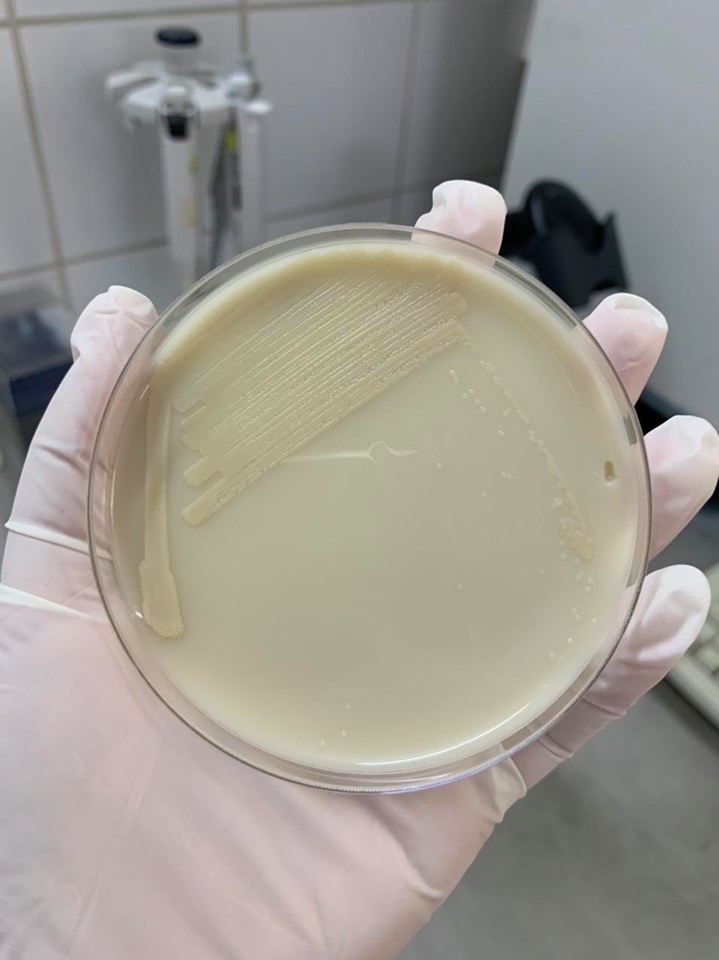

-
 Tháng 7 bùng nổ với 4 bộ phim Hàn Quốc đáng chờ đợi, quy tụ dàn sao đình đám
Tháng 7 bùng nổ với 4 bộ phim Hàn Quốc đáng chờ đợi, quy tụ dàn sao đình đám -
 Nữ thủ khoa tổ hợp A01: Đạt điểm SAT cao nhất thế giới, trúng tuyển ĐH top Hàn Quốc và mê chơi game
Nữ thủ khoa tổ hợp A01: Đạt điểm SAT cao nhất thế giới, trúng tuyển ĐH top Hàn Quốc và mê chơi game -
 Thân thế thủ khoa toàn quốc khối A00, bật mí bí quyết đạt 3 điểm 10 và ngôi trường định đăng ký
Thân thế thủ khoa toàn quốc khối A00, bật mí bí quyết đạt 3 điểm 10 và ngôi trường định đăng ký -
 Nguyên điều tra viên hình sự cao cấp: Vụ phát hiện bộ xương nam MC ở TP HCM là một vụ "án mờ"
Nguyên điều tra viên hình sự cao cấp: Vụ phát hiện bộ xương nam MC ở TP HCM là một vụ "án mờ" -
 Nghi vấn rạn nứt giữa Hoa hậu Thanh Thủy và Trịnh Thăng Bình sau dòng trạng thái lạ
Nghi vấn rạn nứt giữa Hoa hậu Thanh Thủy và Trịnh Thăng Bình sau dòng trạng thái lạ -
 Vụ shipper bị đánh nhập viện vì đơn hàng hơn 2 triệu đồng: Nguyên nhân yêu cầu hoàn tiền bị từ chối
Vụ shipper bị đánh nhập viện vì đơn hàng hơn 2 triệu đồng: Nguyên nhân yêu cầu hoàn tiền bị từ chối -
 Ô tô lao lên vỉa hè tông 2 người ở Lào Cai rồi rời hiện trường, danh tính chủ phương tiện lộ diện
Ô tô lao lên vỉa hè tông 2 người ở Lào Cai rồi rời hiện trường, danh tính chủ phương tiện lộ diện -
 Chính thức mở hệ thống đăng ký nguyện vọng đại học năm 2026: Những lưu ý trọng tâm thí sinh cần biết
Chính thức mở hệ thống đăng ký nguyện vọng đại học năm 2026: Những lưu ý trọng tâm thí sinh cần biết -
 Va chạm giữa ô tô và xe máy trong đêm trên đường Hồ Chí Minh, 3 người thương vong
Va chạm giữa ô tô và xe máy trong đêm trên đường Hồ Chí Minh, 3 người thương vong -
 Thảm kịch động đất kép tại Venezuela: Số người tử vong tăng vọt, quốc gia tuyên bố quốc tang
Thảm kịch động đất kép tại Venezuela: Số người tử vong tăng vọt, quốc gia tuyên bố quốc tang
Xã hội
26/08/2020 04:36Nam công nhân chăn lợn suy đa tạng vì vi khuẩn Whitmore tấn công
Bệnh nhân là nam giới, 45 tuổi, tiền sử khoẻ mạnh, đang làm việc trong Trại nuôi lợn ở khu công nghiệp thuộc tỉnh Bắc Giang. Cứ 3-4 tháng, bệnh nhân mới về thăm gia đình (Tân Lạc, Hoà Bình) một lần.
Trong đợt bùng phát Covid-19 lần thứ 2 này, bệnh nhân cùng những người công nhân khác đã quyết định không về thăm quê và ở lại khu công nghiệp. Công việc hằng ngày của các công nhân ở đây là cho lợn ăn, tắm rửa cho lợn và vệ sinh chuồng trại.
Bệnh nhân xuất hiện sốt cao liên tục 3 ngày và khó thở tăng dần nên phải về quê để khám bệnh. Khi nhập y tế cơ sở, bệnh nhân có tình trạng sốt cao liên tục, khó thở và tình trạng viêm phổi nặng.
Với tình trạng việm phổi nặng, nhiễm trùng-nhiễm độc và yếu tố dịch tễ không rõ ràng như vậy, y tế cơ sở đã chủ động cách ly bệnh nhân để điều trị và phối hợp với Trung tâm kiểm soát dịch bệnh (CDC) của tỉnh, làm xét nghiệm (RT-PCR) sàng lọc Covid-19. Mặc dù chưa có kết quả RT-PCR nhưng bệnh nhân bị suy hô hấp tiến triển, kèm theo tình trạng sốc nhiễm khuẩn nên được hội chẩn chuyển đến Bệnh viện Đa khoa tỉnh Hoà Bình.
Khi nhập Bệnh viện Đa khoa tỉnh Hoà Bình, bệnh nhân được bố trí ở khu vực cách ly, các nhân viên y tế cũng được cách ly tạm thời để điều trị và chăm sóc bệnh nhân.

TS BS Hoàng Công Tình - trưởng khoa Hồi sức cấp cứu của Bệnh viện Đa khoa tỉnh Hoà Bình cho biết bệnh nhân có tình trạng suy hô hấp, tụt huyết áp, suy thận cấp, suy gan cấp, tổn thương phổi lan toả 2 bên. Bệnh nhân trong tình trạng lơ mơ nên không khai thác được yếu tố dịch tễ.
Với tình trạng viêm phổi nặng, cùng với yếu tố dịch tễ không rõ ràng như vậy, Bệnh viện Đa khoa tỉnh Hoà Bình đã chủ động phòng ngừa Covid-19 bằng cách bố trí khu riêng biệt để điều trị và chăm sóc bệnh nhân, đồng thời phối hợp với CDC của tỉnh để có kết quả RT-PCR trong thời gian sớm nhất.
Bên cạnh đó, bệnh nhân cũng được chỉ định nuôi cấy máu, cấy đờm để tìm nguyên nhân do vi khuẩn hoặc vi nấm. Được sử dụng kháng sinh phổ rộng, phối hợp kháng sinh. Hỗ trợ các tạng suy bằng thở máy, lọc máu liên tục và thay huyết tương.
Ngay trong đêm, CDC thông báo kết quả RT-PCR âm tính. Ngày hôm sau, bác sĩ tiếp tục hội chẩn với CDC để xét nghiệm RT-PCR lần 2 và ngay trong đêm cũng cho kết quả âm tính.
Sau khi loại trừ Covid-19, các bác sĩ đã tập trung tìm nguyên nhân gây viêm phổi-sốc nhiễm khuẩn-suy đa tạng. Hai hôm sau, kết quả cấy máu phân lập được vi khuẩn dậy bệnh Whitmore (melioidosis)-căn bệnh vẫn được đồn đoán là "vi khuẩn ăn thịt người".
TS Tình cho biết điều đó không có gì ngạc nhiên khi môi trường làm việc hằng ngày của bệnh nhân thường xuyên tiếp xúc với bùn đất, chỉ một vết trầy xước nhỏ trên da cũng có thể là nơi xâm nhập của loại vi khuẩn gây bệnh này.
Bệnh Whitmore do trực khuẩn Gram âm Burkholderia pseudomallei gây nên (chưa có vaccine dự phòng). Vi khuẩn này có trong đất và đường lây nhiễm chủ yếu do vùng da tổn thương tiếp xúc với đất nhiễm khuẩn hoặc bệnh nhân hít phải các hạt bụi đất chứa vi khuẩn này. Bệnh thường xảy ra vào mùa mưa, tập trung từ tháng 6 đến tháng 11 hàng năm.
BS Tình cho biết những người có sẵn các bệnh lý mạn tính như: đái tháo đường, bệnh thận mạn tính, bệnh phổi mạn tính... dễ bị mắc Whitmore. Khi xâm nhập vào cơ thể con người, vi khuẩn này có thể gây nhiễm khuẩn với các mức độ khác nhau: nhiễm khuẩn tại chỗ (khu trú), nhiễm khuẩn toàn thân(nhiễm khuẩn huyết), sốc nhiễm khuẩn hoặc suy đa tạng.
Những trường hợp tử vong thường do bệnh ở giai đoạn muộn, khi đã có tình trạng nhiễm khuẩn huyết, sốc nhiễm khuẩn hoặc suy đa tạng. Số ca bệnh Whitmore xuất hiện nhiều hơn trong những năm gần đây là do các cơ sở y tế đã cảnh giác hơn đến loại vi khuẩn này; các kỹ thuật nuôi cấy phân lập vi khuẩn Burkholderia pseudomallei ngày càng tiến bộ, hạn chế bỏ sót các ca bệnh.
Để phòng bệnh, theo bác sĩ Tình cần hạn chế tiếp xúc với đất hoặc bùn nước, đặc biệt là những ô nhiễm. Trang bị đầy đủ giày, dép và găng tay đối với những người thường xuyên phải làm việc ngoài trời, tránh tiếp xúc trực tiếp với đất và nước nhiễm bẩn.
Khi có vết thương hở trên da, vết loét hoặc bỏng, bệnh nhân cần tránh tiếp xúc với đất hoặc nước có nguy cơ bị ô nhiễm và chứa vi khuẩn.
Theo Ngọc Anh (Pháp Luật & Bạn Đọc)








- Đội tuyển Việt Nam sang Hàn Quốc tập huấn, HLV Kim Sang-sik mang theo lực lượng mạnh nhất (15:38)
- Bảng giá iPhone cũ tháng 7: Giảm thủng đáy, iPhone 14 chỉ từ 10 triệu đồng, iPhone 13 cũ rẻ như cho (15:34)
- Thượng đỉnh tiền số và tài sản tăng vọt: Tổng thống Donald Trump phá vỡ im lặng về khoản thu nhập 1,2 tỷ USD (15:15)
- 5 dấu hiệu xuất hiện khi ngủ cảnh báo tim, thận đang gặp vấn đề: Nhiều người tưởng do tuổi tác nên bỏ qua (15:15)
- Doanh thu gần 835 tỷ đồng nhưng bị cáo buộc trốn thuế hơn 12,5 tỷ, nữ chủ shop đồ hiệu bị đưa ra xét xử (43 phút trước)
- Tháng 7 bùng nổ với 4 bộ phim Hàn Quốc đáng chờ đợi, quy tụ dàn sao đình đám (43 phút trước)
- Nhận định Thụy Sĩ vs Algeria: Bản lĩnh lên tiếng (44 phút trước)
- Nữ thủ khoa tổ hợp A01: Đạt điểm SAT cao nhất thế giới, trúng tuyển ĐH top Hàn Quốc và mê chơi game (49 phút trước)
- Nam thanh niên bị nước cuốn khi chạy xe máy qua cầu tạm (59 phút trước)
- Vụ du khách rơi khỏi dù lượn tử vong ở Đà Nẵng: Bản án cuối cùng cho phi công quên cài khóa an toàn cho khách (1 giờ trước)
Bài đọc nhiều












